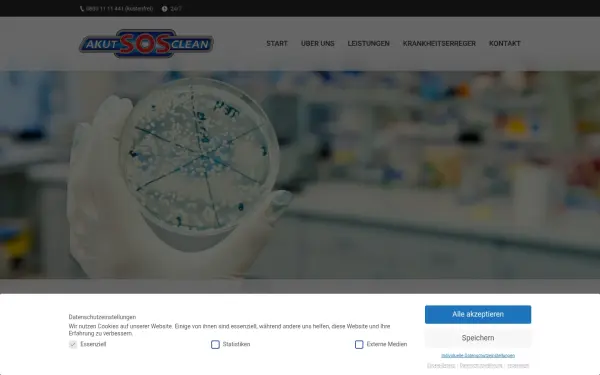

Falls du jedoch lieber den Überblick der Website alanwake.com sehen möchtest, dann klicke bitte hier .
akut-desinfektion.de
Start - Akut Desinfektion
Sprache: Deutsch
Charset: utf-8
Generator: Powered by Visual Composer - drag and drop page builder for WordPress.
Robots-Anweisung: index, follow, max-video-preview:-1, max-snippet:-1, max-image-preview:large
Viewport: width=device-width, initial-scale=1, maximum-scale=1
Sicherheit und Einstufung
Die Website enthält laut CLOUDFLARE keine bedenklichen Inhalte und kann sowohl von Minderjährigen als auch in der Arbeit genutzt werden.
Rechtliches / Kontakt
Impressum:
https://akut-desinfektion.de/impressum/
Kontakt:
https://akut-desinfektion.de/kontakt/
Der Betreiber dieser Domain befindet sich in 60325 Frankfurt am Main
Sämtliche Sub-Domains der Haupt-Domain
akut-desinfektion.de
akut-desinfektion.de
Verwendete Technologien
-
Apache HTTP Server
Apache ist eine freie und quelloffene, plattformübergreifende Webserver-Software.
-
jQuery Migrate
Query Migrate ist eine Javascript-Bibliothek, die es Ihnen ermöglicht, die Kompatibilität Ihrer jQuery-Code für Versionen von jQuery älter als 1.9 entwickelt zu bewahren.
-
jQuery
jQuery ist eine JavaScript-Bibliothek, eine kostenlose Open-Source-Software, die das Traversieren und Manipulieren des HTML-DOM-Baums sowie die Ereignisbehandlung, CSS-Animation und Ajax vereinfacht.
-
MySQL
MySQL ist ein quelloffenes relationales Datenbankmanagementsystem.
-
Open Graph
Open Graph ist ein Protokoll, das dazu dient, jede beliebige Webseite in den Social Graph zu integrieren.
-
PHP
PHP ist eine universelle Skriptsprache für die Webentwicklung.
-
WordPress
WordPress ist ein kostenloses und quelloffenes Content-Management-System, das in PHP geschrieben und mit einer MySQL- oder MariaDB-Datenbank gekoppelt ist. Zu den Funktionen gehören eine Plugin-Architektur und ein Vorlagensystem.
-
Yoast SEO
Yoast SEO ist ein Plugin zur Suchmaschinenoptimierung für WordPress und andere Plattformen.
DNS-Einträge
IP-Adresse Server:
92.51.167.108